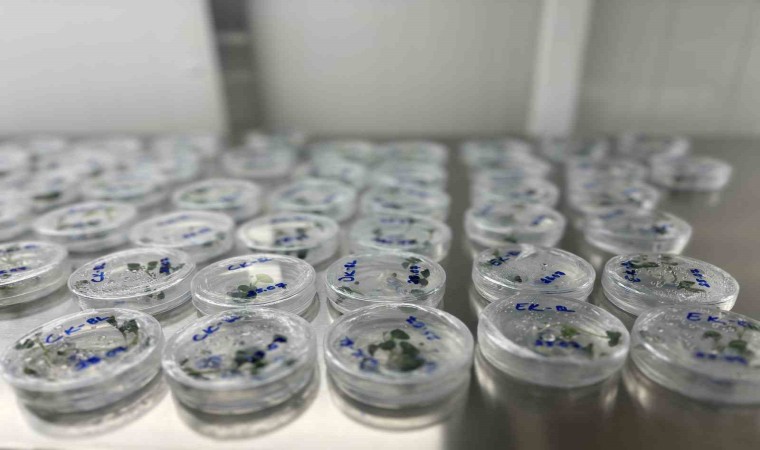

İsrail’in dünyaya sattığı kısırlaştırılmış tohumlar, yerini ata tohumlarına bırakıyor. Islah projelerinde geliştirilen ata tohumları, çiftçilerin kullanımına sunularak ülke ekonomisine kazandırılacak.
Tek kullanımlık kısırlaştırılmış tohumları dünya geneline satan İsrail’e karşı yerli ve milli ata tohumların geliştirmesi için çalışmalar sürüyor. Herhangi bir savaş durumunda Türkiye’nin gıda sorunu yaşamaması için mücadele eden Türk bilim adamları; kaliteli ve verimi yüksek buğday cinsi çalışmaları yürütüyor. Ülke tarımını ileriye taşımak isteyen bilim insanları, buğday çeşit adaylarını geliştirerek, her türlü hava ve doğa şartlarına mukavemetli hububat ürünlerini geliştiriyor. Konuya ilişkin açıklama yapan Sivas Bilim ve Teknoloji Üniversitesi Tarım Bilimleri ve Teknolojileri Fakültesi Dekanı Prof. Dr. Tolga Karaköy, gıdaya erişimin çok önemli olduğunu belirterek, “Savunma sanayi ne kadar önemliyse en az bunun kadar kıymetli ve önemli olan şey gıdadır” dedi.
Pandemi döneminde gıdanın çok önemli olduğunun görüldüğünü ifade eden Prof. Dr. Tolga Karaköy, “Gıdaya erişimin süreklilik göstermesi de son derece kıymetli. Savaş ve benzeri sebepler için savunma sanayi ne kadar önemliyse en az bunun kadar kıymetli ve önemli olan şey gıdadır. Gıdaya olan erişim ve ihtiyaç son derece kıymetlidir. Bizim her şeyden önce yapmamız şey ülke olarak dışa bağımlı olduğumuz ürün gruplarını azaltmaya yönelik AR-GE çalışmasına ağırlık vermek zorundayız. Savunma sanayinde Ar-Ge çalışmasına ayırdığımız bütçeyi aynı şekilde tarımsal çalışmalara da ayırmak zorundayız. 2030’lu yıllara geldiğimiz zaman nüfusun 90 milyonu bulması bekleniyor. Bu nüfusu besleyebilecek bir potansiyele sahip olmalıyız. Günümüzde yaşanan olaylara baktığımızda 3. Dünya savaşına dair söylentiler var ve yaşanması da muhtemel. Bundan dolayı ata tohumlarımızı mutlak suretle depolayıp rezervlerimizde tutmalıyız çünkü zamanı geldiğinde o tohumlara erişim noktasında sorunlar yaşayabiliriz” dedi.
Ata tohumu ıslah çalışmaları hızla sürüyor
Sivas’ta ata tohumu çalışmalarını sürdürdüklerini ifade eden Karaköy, “Çiftçilerimizle yaptığımız çalışmalarda bu tohumları genel olarak karışık tohumlar. Yıllardır elden ele geldiği için ister istemez saflığını bir bakıma yitirmiş tohumlardır. Biz bunları saflaştırdık ve şu anda çiftçilerimize de dağıtıyoruz. Çiftçilerimize de ekileceği tarlada en az 4 yıl buğday ekilmemiş olması gerektiğini söylüyoruz. Bu şekilde nesilden nesle aktarılmasını, aktarıldıktan sonra da bahse konu dönemlerde yerli çeşitlerimizi kullanabilelim. Ata tohumlarını kullandığımız bir diğer önemli nokta da şu ki ıslah çalışmalarımız. Ata tohumlarımız kalite olarak çok çok üstünler. Verim potansiyelleri düşük, hastalıklara karşı hassaslar ama daha kaliteli tohumlar alabilmek için ebeveyn olarak kullanıyoruz. Ata tohumlarımızın kanını taşıyan çeşit adaylarımız var. Kısmetse onları da yerli ve milli çeşit aday olarak tescil ettireceğiz. Ve bunları çiftçilerimizin kullanımına sunmuş olacağız. Bahsettiğimiz ata tohumlarının saklanması çok önemli. Bizim de ıslah çalışmalarında sakladığımız depolarımız var. Ülkemizde 2 tane gen bankamız var. Bahsettiğimiz gen kaynaklarımız İzmir ve Ankara’da saklanıyor. Olağanüstü durumların oluşmasında da devletimiz gerekli önlemleri alarak insanların uzun süre beslenmesini sağlayacaktır” şeklinde konuştu.

Yorum Yazın
E-posta hesabınız sitede yayımlanmayacaktır. Gerekli alanlar * ile işaretlenmişdir.